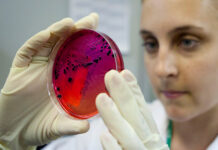
Спалах сальмонельозу в Калинівці: 29 постраждалих, серед них — діти

Мітка: сальмонельоз
Спалах сальмонельозу в Калинівці: 29 постраждалих, серед них — діти
У Калинівці зафіксовано спалах гострої кишкової інфекції, спричиненої сальмонелою. Станом на ранок 2 липня вже зареєстровано 29 випадків захворювання, з яких десятеро – діти...